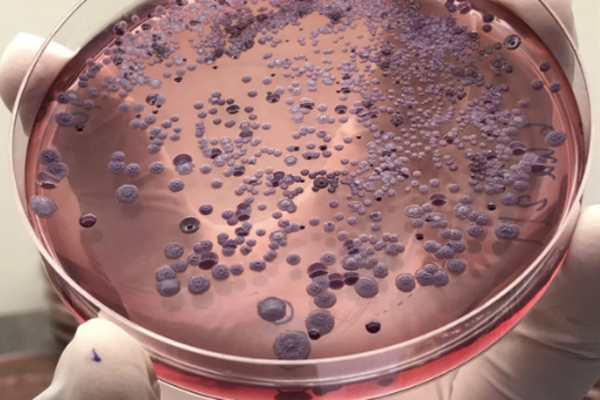

-
- Chính trị
- Thời sự
- Kinh doanh
- Dân tộc và Tôn giáo
- Thể thao
- Giáo dục
- Thế giới
- Đời sống
- Văn hóa - Giải trí
- Sức khỏe
- Công nghệ
- Ô tô xe máy
- Du lịch
- Bất động sản
- Bạn đọc
- Tuần Việt Nam
- Công nghiệp hỗ trợ
- Giảm nghèo bền vững
- Nông thôn mới
- Dân tộc thiểu số và miền núi
- Nội dung chuyên đề
- English
- Hồ sơ
- Ảnh
- Video
- Multimedia
- Podcast
- Đính chính
- 24h qua
- Cơ quan chủ quản: Bộ Dân tộc và Tôn giáo
- Số giấy phép: 146/GP-BVHTTDL, cấp ngày 17/10/2025
- Tổng biên tập: Nguyễn Văn Bá
- Địa chỉ: Tầng 18, Toà nhà Cục Viễn thông (VNTA), 68 Dương Đình Nghệ, phường Cầu Giấy, TP. Hà Nội.
- Điện thoại: 02439369898 - Hotline: 0923457788
- Email: vietnamnet@vietnamnet.vn
- © 1997 Báo VietNamNet. All rights reserved.
- Chỉ được phát hành lại thông tin từ website này khi có sự đồng ý bằng văn bản của báo VietNamNet.
- Công ty Cổ phần Truyền thông VietNamNet
- Hotline: 0919 405 885 (Hà Nội) - 0919 435 885 (Tp.HCM)
- Email: contact@vietnamnet.vn
- Báo giá: http://vads.vn
- Hỗ trợ kỹ thuật: support@tech.vietnamnet.vn

- Mẫu đất nhiễm khuẩn Whitmore được lấy ở độ sâu dưới 90cm trong khu vực sinh hoạt của gia đình.
- Mẫu đất nhiễm khuẩn Whitmore được lấy ở độ sâu dưới 90cm trong khu vực sinh hoạt của gia đình.
